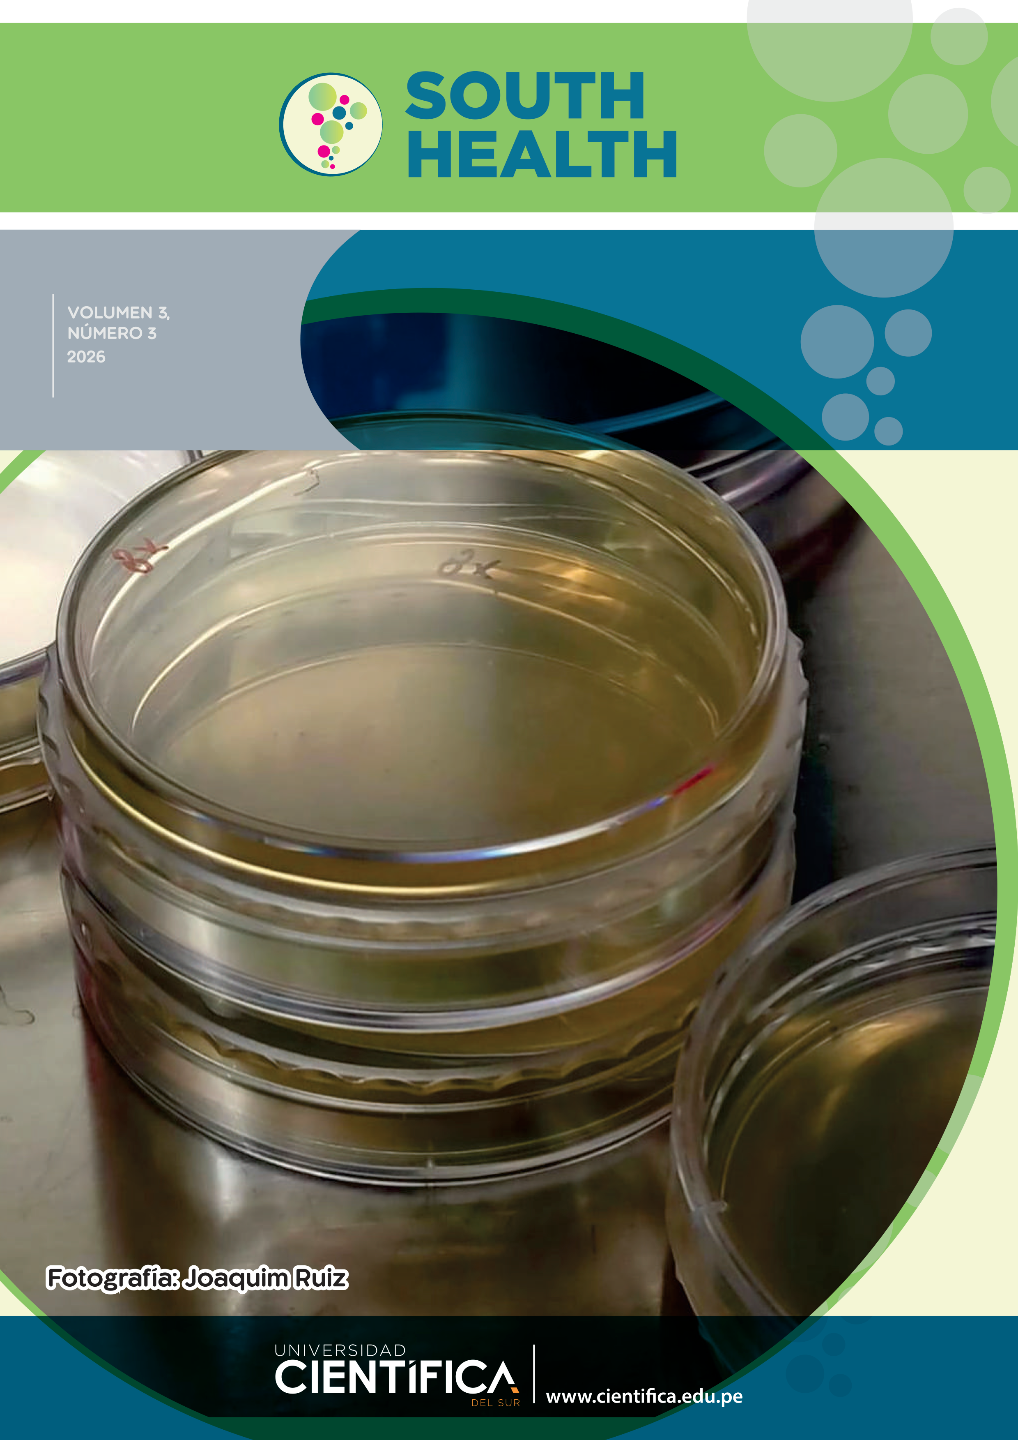
View Vol. 3 (2026)

Announcements
Current Issue
Review
Open call for authors
South Health, a platinum open access (free of charges for authors, free of charges for readers) accepts articles focused on microorganisms and their interactions with hosts and environments in and beyond human health, including basic research, environmental, human or animal issues and/or their interfaces will be considered. Bacteriological, Virological, Mycological, Parasitological, Protistological, Immunological as well as Metagenomic approaches are welcomed.







